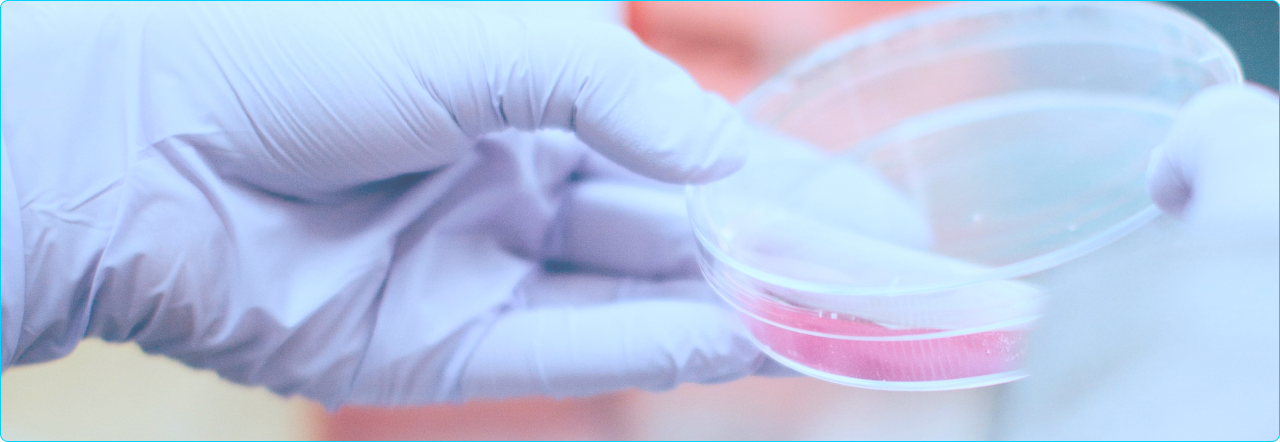
Life Sciences Lab

Solutions > Healthcare & Life Sciences


















THE CHALLENGE
Wrong Answers in Healthcare Costs
Time, Money, and Lives
Your most critical decisions hang on incomplete answers.
Like that patient outcomes analysis needed for the regulatory` meeting next week, or the safety insights buried somewhere across three CRO databases that could derail a $200 million reimbursement. Then there’s the payer mix and changing coverage that affect market access.
In healthcare and life sciences, being wrong or late doesn't just cost revenue. It affects patients’ health. But clarity doesn't have to come late.
HEALTHCARE & LIFE SCIENCES SOLUTIONS
The Agentic Analytics Platform For
Healthcare And Life Sciences
Healthcare And Life Sciences
R&D
Use real-world data (RWD) and R&D data to optimize portfolio pipeline, resources, and investments.
Clinical Trials
Identify tria sites, monitor patient recruitment & retention, and catch protocol deviations before timelines slip and costs compound.
Supply Chain
Ensure on-time deliveries, manage procurement spend, and catch inventory stockouts before they impact care.
Commercialization & Market Access
Connect sales, marketing, and population health data to track prescriptions, HCP engagement, and sales forecasts.
Safety/Quality
Detect adverse event patterns early using across real-world data and pharmacovigilance sources to ensure patient safety.
Claims Optimization
Reduce denials, detect fraud, and prevent reimbursement leakage with near-real-time visibility into claims data.
Provider Engagement
Improve the performance of digital campaigns and marketing efforts to drive engagement with healthcare professionals.
Healthcare Operations
Streamline hospital operations, provider productivity, and throughput metrics like length of stay (LOS) leading to improved access and outcomes.
Higher Customer
Satisfaction
Satisfaction
Increase in Clinician
Access to Patient
Insights
Access to Patient Insights
Internal Adoption
Rate
Rate
PLATFORM CAPABILITIES
An Analyst At Your Fingertips,
Trained For Healthcare And Life Sciences


Intelligence At Scale
or query
resolution backlogs, and get answers
grounded in your EDC, CTMS, and safety
data with full lineage. No more
waiting
on EMR exports or reconciling
conflicting spreadsheets before
leadership calls.

Your Metrics, Your Logic, Your Language
Spotter Semantics ensures every answer is grounded in your governed definitions. Whether it's screening failure rates, database lock timelines, or denial rates, Spotter speaks your language. Teach it edge cases and business rules in plain language with Spotter Instructions, so answers reflect how your organization actually defines success.
EXPLORE SPOTTER SEMANTICS
Connect Your Healthcare & Life Sciences Stack
Your data warehouse holds part of the story. Spotter Connectors bring in the rest from CRO systems, EDC platforms, regulatory documentation, claims feeds, and provider networks. With complete business context via MCP integration, Spotter reasons across clinical, safety, and financial data without forcing you to consolidate everything first.
EXPLORE SPOTTER CONNECTORS
From Clinical Data to Dashboard, Automatically
SpotterViz is a dashboarding agent that generates production-ready dashboards tailored to life sciences workflows in minutes, not weeks. Need waterfall charts for enrollment funnels or heat maps for geographic claims patterns? Muze delivers visualization types built for the analytical complexity your teams demand, with no analyst queue required.
EXPLORE SPOTTERVIZ
AI Built for Healthcare Regulations
You get row-level and column-level security with role-based access controls to ensure full patient data privacy and security. Audit-ready conversation monitoring. Bring your own LLM, and don’t worry about data retention. Enterprise AI Trust means your compliance team, your board, and your regulators can verify exactly how AI operates in your environment. Because in healthcare and life sciences, trust isn't optional.
EXPLORE ENTERPRISE AI TRUSTRESOURCES
See How Life Sciences Leaders
Use ThoughtSpot
FEATURED CASE STUDY
How Midas Pharma Transformed Commercial Analytics With ThoughtSpot
Midas Pharma, a global pharmaceutical company, replaced static Excel reports with ThoughtSpot's agentic analytics platform. Within four months, they achieved:
- 70% internal adoption across commercial and R&D teams
- Generated over 10,000 new visualizations per month
- Delivered 99% of queries in under one second , enabling faster market access decisions and trial oversight
INFRASTRUCTURE
The Technical Foundation Life
Sciences Demands
 SOC 2 Type II and HIPAA compliant
SOC 2 Type II and HIPAA compliant
 Integrates with Snowflake and Databricks
Integrates with Snowflake and Databricks
 Row-level and column-level security
Row-level and column-level security
 Bring your own LLM support
Bring your own LLM support
 No data retention policies
No data retention policies
 Full audit trail and lineage tracking
Full audit trail and lineage tracking
 API and SDK for embedded analytics
API and SDK for embedded analytics
 FedRAMP authorized options available
FedRAMP authorized options available
Frequently Asked Questions
Our audit logs track every query and interaction for
compliance reporting. Additionally, our
bring-your-own-LLM capability means you can use
models hosted in your own environment, and our
no-data-retention policy ensures prompts and
responses are never stored by ThoughtSpot.









